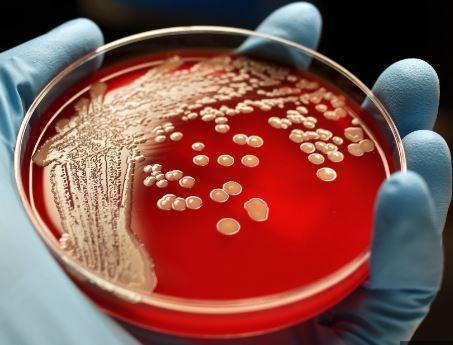

We hear daily, how often patients take over the counter (OTC), medication. Many have the idea these medications cause no harm, and daily intake is okay. The use of these drugs, can cause harm and frequent use will have negative effects on your body.
This new research from the University of South Australia, showed how these drugs fuel the superbugs that contribute to antibiotic resistance. When they are used together they amplify the resistance even more. In the study, when E. coli was exposed to ciprofloxacin alongside ibuprofen and acetaminophen – both alone and especially when combined – the painkillers significantly increased genetic mutations in the bacteria.
In 2019, drug-resistant bacteria were directly responsible for 1.27 million deaths and were associated with nearly five million deaths.
As Chiropractors, we educate our patients on keeping their body healthy and maintaining your immune system strong through Chiropractic care and nutrition. We believe there is a paradigm shift happening in health care. Patients are becoming more knowledgeable about health and challenging the system, which kept them on drugs and in turn maintained their disease manageable. Who wants their disease managed? We want to be cured and live a life without taking drugs.
Educate yourself, on become your own advocate and you will thrive for years to come.
Reference: Khloe Quill Fox News, Published August 28, 2025 9:44am EDT
